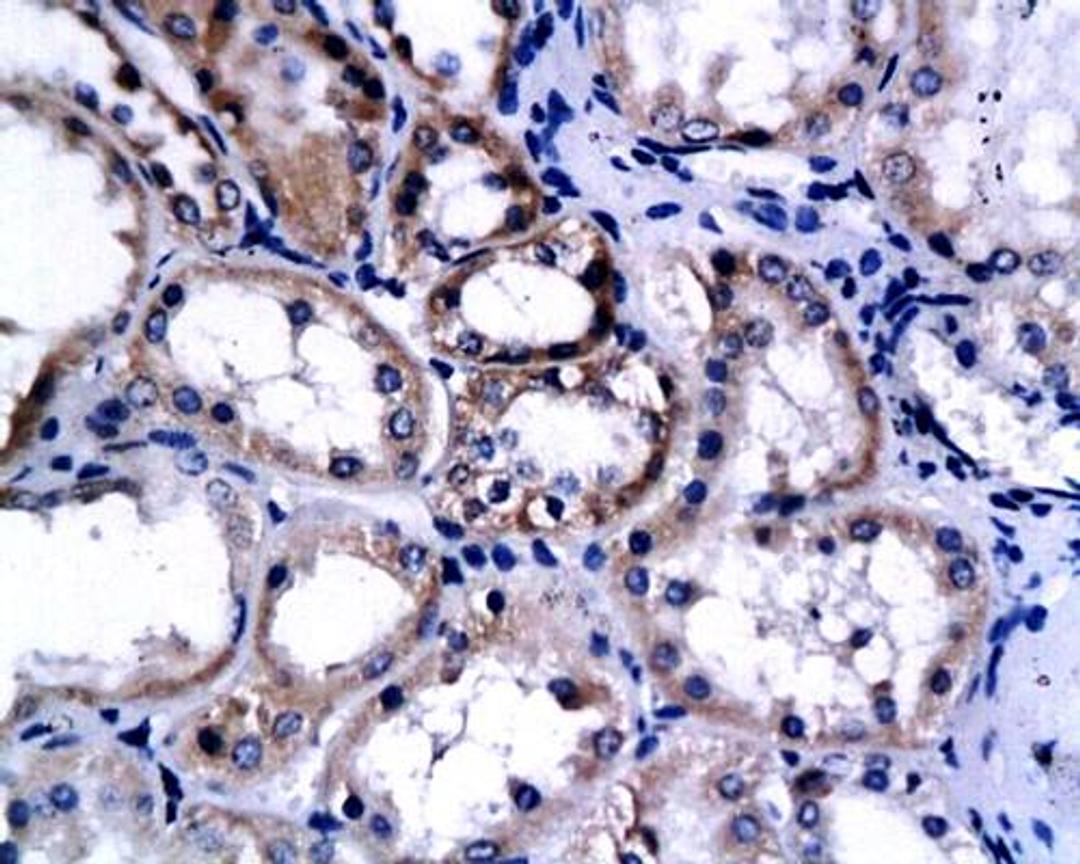
Immunohistochemical analysis of paraffin-embedded human renal cell carcinoma using Endostatin antibody

Product & ReviewsAntibodies
HPV16 E7 antibody
Product Details
- Cat. No.
- orb10573
- Type
- Primary Antibody
- Clonality
- Polyclonal
- Host
- Rabbit

The supplier does not provide quotations for this antibody through SelectScience. You can search for similar antibodies in our Antibody Directory.
Description
Rabbit polyclonal antibody to SLC22A3 and is also known as protein E7 whose expression can be detected in the early protein. It is found in the host cytoplasm and host nucleus. This protein plays an effective role in viral genome replication by driving en
Biological Information
- Clonality: Polyclonal
- Host: Rabbit
- Reactivity: Human
- Isotype: IgG
Handling
- Quantity: 50 µl, 100 µl, 20 µl (Trial size)
- Storage: Store at -20°C.Stable for 12 months from date of receipt.
- Buffer: Phosphate buffer saline, pH. 7.4, 150mM NaCl, 0.02% sodium azide and 50% glycerol.
Applications
- ELISA (ELISA)
- Immunofluorescence (Paraffin-Embedded Sections) (IF (P))
- Immunohistochemistry (Frozen Sections) (IHC (Fr))
- Immunohistochemistry (Paraffin-Embedded Sections) (IHC (P))